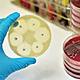
Images

-
Francis Bancon revive la hipótesis de las criaturas invisibles y plantea que estas causan enfermedades
-
Fracastorius aplica el concepto de transmisibilidad a la sífilis
-
Antoni Van Leeuwenhoek Invento el primer microscopio y describió lo que llamo animálculos
-
Se produce de la mano de Louis Pasteur con sus estudios sobre la fermentación y de Robert kosh que establece los fundamentos de infectología
-
En el Siglo XVII también se atacó desde la ciencia a la teoría de la generación espontánea. Esta última suponía que los seres vivos podían originarse de materia inanimada, del aire o de desechos en descomposición. https://www.lifeder.com/historia-de-la-microbiologia/
-
Gracias a los avances de Louis Pasteur en la microbiología surgirían los antibióticos, la esterilización y la higiene clínica como métodos efectivos para la cura y la prevención de propagación de enfermedades. https://fmcreciendo.com.ar/nota/3717/pasteur-edad-de-oro-de-la-microbiologia
-
En 1857 Pasteur demuestra que las infecciones están relacionadas con los microorganismos, que se pueden cultiva. https://fmcreciendo.com.ar/nota/3717/pasteur-edad-de-oro-de-la-microbiologia
-
Años después, en 1880,Louis Pasteur comprueba que es posible protegerse de las enfermedades infecciosas mediante la inyección de gérmenes atenuados. https://fmcreciendo.com.ar/nota/3717/pasteur-edad-de-oro-de-la-microbiologia
-
En 1877 mostró cómo esterilizar por calor discontinuo. Esta forma demostró que existían microorganismos muy resistentes al calor.
https://www.lifeder.com/historia-de-la-microbiologia/ -
Koch introdujo el concepto de especie a los microorganismos, con características y funciones distintivas. También en 1882, Koch fue el descubridor del bacilo de la tuberculosis y, en 1883, el bacilo del cólera.
https://www.lifeder.com/historia-de-la-microbiologia/ -
la infectología se estableció como un área de la microbiología donde se destacaron y paul halló un tratamiento para la sífilis y dió inicio a la llamada quimioterapia https://www.lifeder.com/historia-de-la-microbiologia/
-
Descubrió la penicilina, el primero de los antibióticos. https://www.lifeder.com/historia-de-la-microbiologia/
-
se posibilitaron los estudios de la composición de la sangre y sus diagnósticos, la obtención de vacunas para diversas enfermedades, la virología o estudio de los virus. https://www.lifeder.com/historia-de-la-microbiologia/
-
La creación de retrovirus para enfermedades como el Síndrome de Inmunodeficiencia Adquirida (SIDA), entre otros.
Looking for a timeline maker?
Create timelines for projects, roadmaps, history, lessons, legal cases, and stories with Timetoast. Timetoast is a timeline maker for work, school, research, and stories.